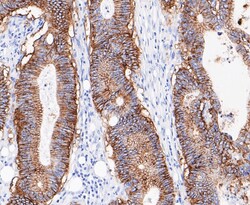

Antibody data
- Antibody Data
- Antigen structure
- References [0]
- Comments [0]
- Validations
- Western blot [1]
- Immunohistochemistry [5]
Submit
Validation data
Reference
Comment
Report error
- Product number
- MA5-34867 - Provider product page

- Provider
- Invitrogen Antibodies
- Product name
- A33 Recombinant Rabbit Monoclonal Antibody (JE49-54)
- Antibody type
- Monoclonal
- Antigen
- Recombinant full-length protein
- Description
- Positive Control: Human small intestine tissue, human colon tissue, human colon cancer tissue, human appendix tissue.
- Reactivity
- Human
- Host
- Rabbit
- Isotype
- IgG
- Antibody clone number
- JE49-54
- Vial size
- 100 μL
- Concentration
- 1 mg/mL
- Storage
- -20°C, Avoid Freeze/Thaw Cycles, store in dark
No comments: Submit comment
Supportive validation
- Submitted by
- Invitrogen Antibodies (provider)
- Main image

- Experimental details
- Western blot analysis of GPA33 in human small intestine tissue lysate. Samples were transferred to PVDF membrane, blocked with 5% BSA (1 hour), incubated with GPA33 monoclonal antibody (Product # MA5-34867), at a dilution of 1:500, followed by Goat Anti-Rabbit IgG-HRP (1 hour) with a dilution of 1:5000.
Supportive validation
- Submitted by
- Invitrogen Antibodies (provider)
- Main image

- Experimental details
- Immunohistochemistry analysis of GPA33 in paraffin-embedded human small intestine tissue. Samples were heat mediated antigen retrieval with Tris-EDTA buffer (pH 8.0-8.4, 20 minutes) and blocked in 5% BSA (30 min, room temperature), incubated with GPA33 monoclonal antibody (Product # MA5-34867) at a dilution of 1:200 (30 min, room temperature), and followed by HRP conjugate, DAB and hematoxylin (mounted with DPX).
- Submitted by
- Invitrogen Antibodies (provider)
- Main image

- Experimental details
- Immunohistochemistry analysis of GPA33 in paraffin-embedded human colon tissue. Samples were heat mediated antigen retrieval with Tris-EDTA buffer (pH 8.0-8.4, 20 minutes) and blocked in 5% BSA (30 min, room temperature), incubated with GPA33 monoclonal antibody (Product # MA5-34867) at a dilution of 1:200 (30 min, room temperature), and followed by HRP conjugate, DAB and hematoxylin (mounted with DPX).
- Submitted by
- Invitrogen Antibodies (provider)
- Main image
- Experimental details
- Immunohistochemistry analysis of GPA33 in paraffin-embedded human colon cancer tissue. Samples were heat mediated antigen retrieval with Tris-EDTA buffer (pH 8.0-8.4, 20 minutes) and blocked in 5% BSA (30 min, room temperature), incubated with GPA33 monoclonal antibody (Product # MA5-34867) at a dilution of 1:200 (30 min, room temperature), and followed by HRP conjugate, DAB and hematoxylin (mounted with DPX).
- Submitted by
- Invitrogen Antibodies (provider)
- Main image

- Experimental details
- Immunohistochemistry analysis of GPA33 in paraffin-embedded human appendix tissue. Samples were heat mediated antigen retrieval with Tris-EDTA buffer (pH 8.0-8.4, 20 minutes) and blocked in 5% BSA (30 min, room temperature), incubated with GPA33 monoclonal antibody (Product # MA5-34867) at a dilution of 1:50 (30 min, room temperature), and followed by HRP conjugate, DAB and hematoxylin (mounted with DPX).
- Submitted by
- Invitrogen Antibodies (provider)
- Main image

- Experimental details
- Immunohistochemistry analysis of GPA33 in paraffin-embedded human colon cancer tissue. Samples were heat mediated antigen retrieval with Tris-EDTA buffer (pH 8.0-8.4, 20 minutes) and blocked in 5% BSA (30 min, room temperature), incubated with GPA33 monoclonal antibody (Product # MA5-34867) at a dilution of 1:200 (30 min, room temperature), and followed by HRP conjugate, DAB and hematoxylin (mounted with DPX).